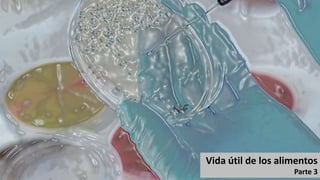
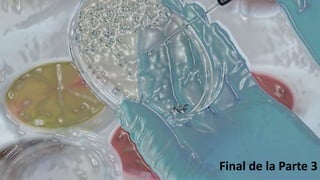
Final de la Parte 3

El documento aborda la conservación de alimentos, explicando métodos como el calor, frío, deshidratación y fermentación, y su impacto en la calidad y seguridad alimentaria. Se detallan factores que afectan la vida útil de los alimentos y la importancia de los criterios microbiológicos para garantizar la inocuidad. También se presentan planes de muestreo y la clasificación de alimentos según su riesgo microbiológico.